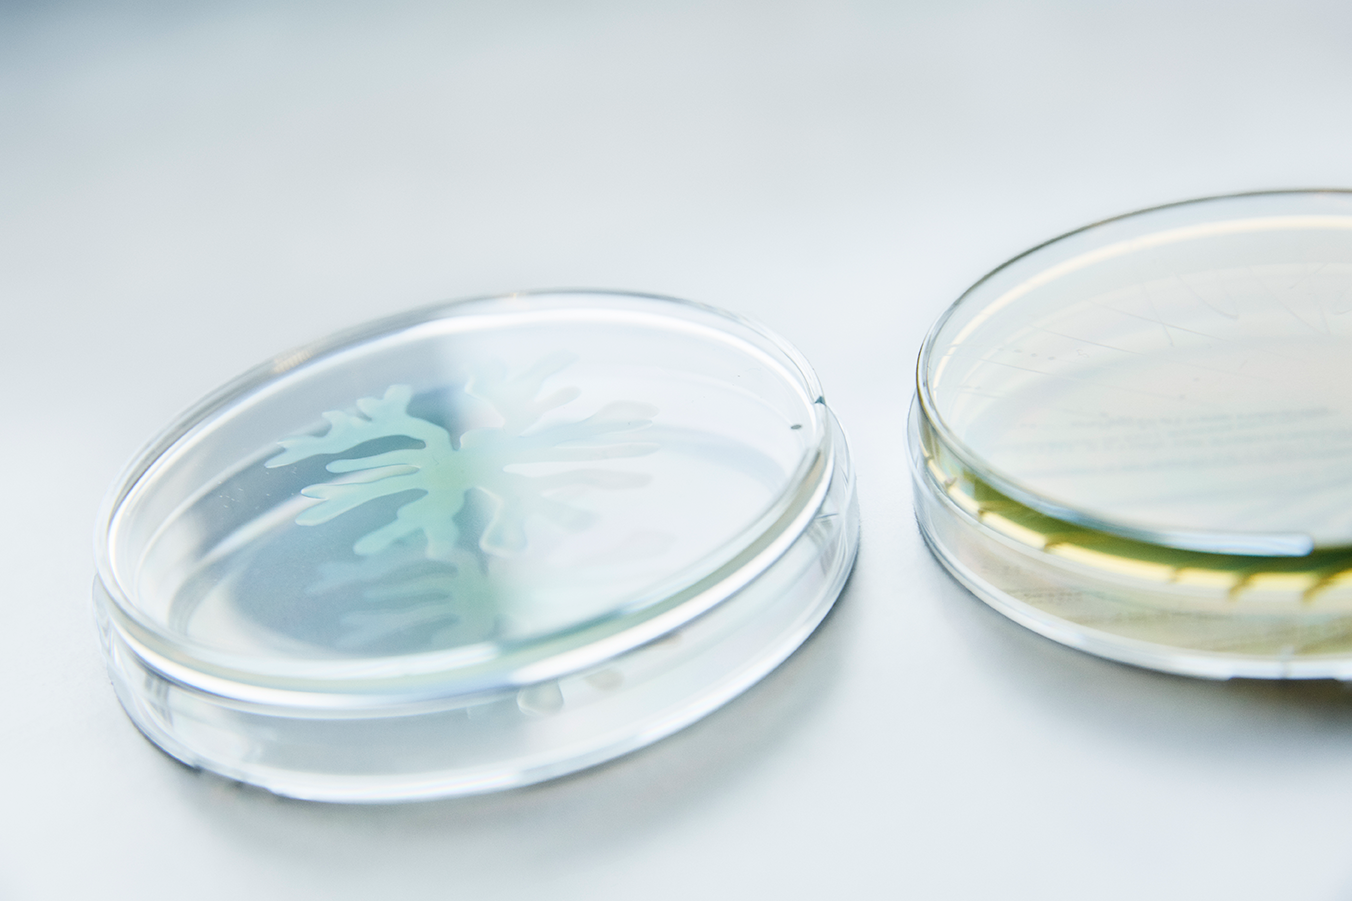
Bacterial Test Tube

Membership and benefits
At Pharmadanmark, we understand our members and the sectors they work in. That’s why we provide fast, qualified support when it comes to legal matters, career decisions, and unemployment.
We’re also here to help you grow professionally and ensure your voice is heard. Every day.


Become a member
Pharmadanmark is the union for Life Science employees — covering the entire field, from research and development to production, regulation, and commercialization.
Why become a member?
At Pharmadanmark, we understand the Life Science sector inside out. That’s why we can provide exactly the support you need—fast and with expert insight.

Membership types and fees
Your Pharmadanmark membership fee is based on your current employment and personal circumstances—so you only pay for what fits your situation.
Need help?
We’re here for you.
If you have any questions or need assistance, you can always contact our Member Services team.
Call us at +45 3946 3600
Email us at pd@pharmadanmark.dk
Opening hours:
Monday–Thursday: 9:30 AM – 4:00 PM
Friday: 9:30 AM – 2:00 PM
